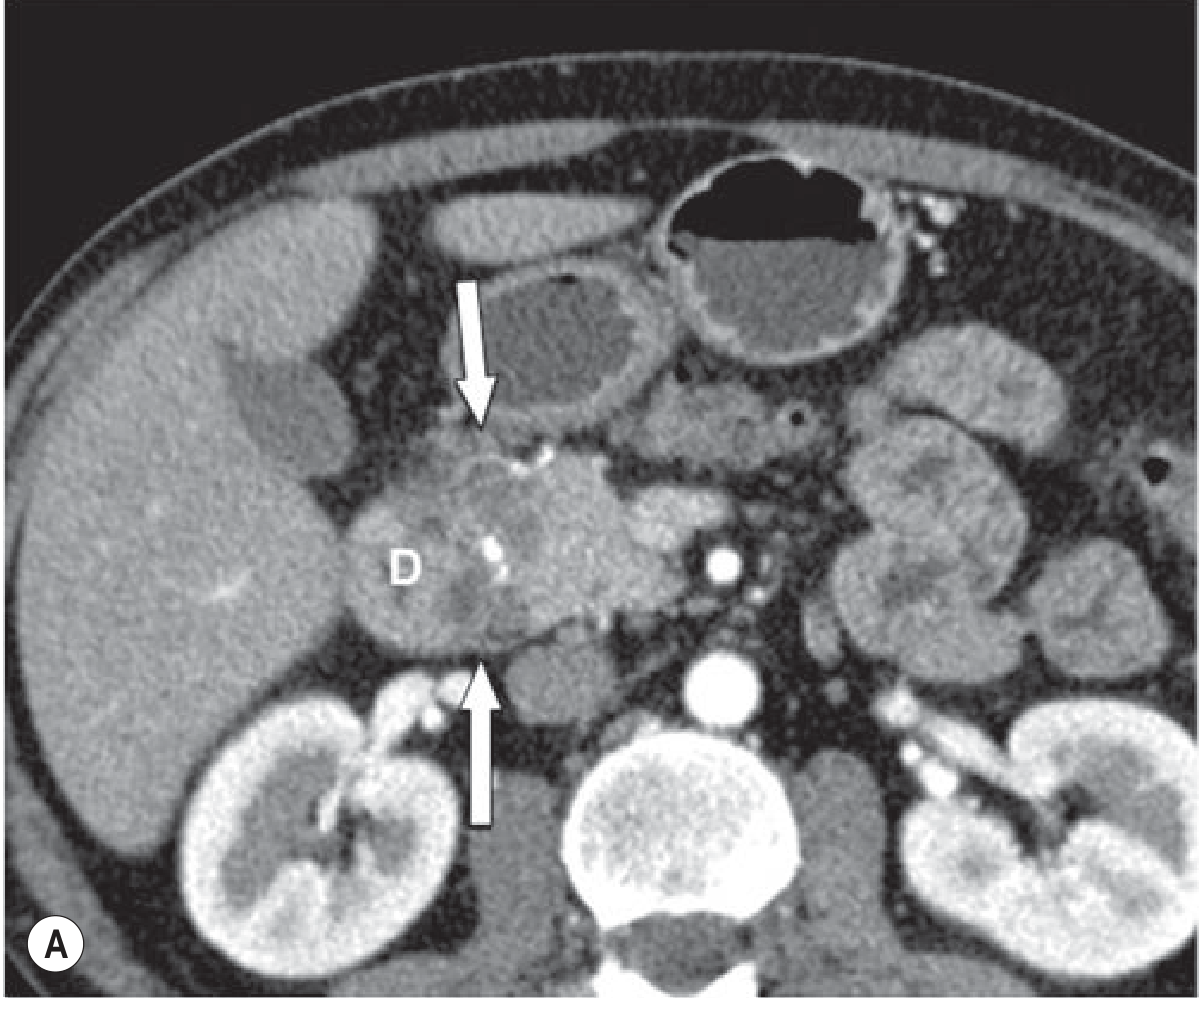

Groove pancreatitis
Reading File
Finding Sources
Finding Sources
Reading File
Reading File
Reading File
Reading File
Reading File
Loading Image
Reading File
Loading Image
Here is a comprehensive overview of groove pancreatitis based on multiple authoritative sources.
Groove (Paraduodenal) Pancreatitis
Definition & Anatomy
Groove pancreatitis — also called paraduodenal pancreatitis or "cystic dystrophy of the duodenum" — is a distinct form of chronic pancreatitis in which inflammation is confined to the pancreatic groove: the space between the head of the pancreas, the duodenum, and the common bile duct, specifically between the major and minor pancreatic papillae. — Current Surgical Therapy 14e, p. 669; Grainger & Allison's Diagnostic Radiology
Epidemiology & Risk Factors
- More common in males
- Strong association with alcohol and tobacco use
- Presents similarly to other forms of chronic pancreatitis in terms of demographics — Current Surgical Therapy 14e, p. 669
Clinical Presentation
- Persistent abdominal pain
- Obstructive jaundice (biliary obstruction)
- Gastric outlet obstruction (duodenal involvement)
- Features of chronic pancreatitis (calcifications, parenchymal atrophy) are found in >35% of cases — Clinical Gastrointestinal Endoscopy 3e, p. 3890
Subtypes (Paraduodenal Classification)
Recent studies define four subtypes:
| Type | Description |
|---|---|
| 1A | Solid, groove-predominant — mass between duodenum and pancreatic head |
| 1B | Solid, pancreas-involving — cancer-mimicking mass in head-groove area |
| 2A | Cyst-forming, groove-predominant (classic appearance) |
| 2B | Cyst-forming, pancreas-involving (segmental) |
The groove-predominant form and the segmental/pancreas-involving form are the two main radiological patterns. — Grainger & Allison's, p. 692
Imaging
CT findings:
- Plate-like hypoattenuating, poorly enhancing lesion between the pancreatic head and descending duodenum
- Diffuse stranding and inflammatory changes surrounding the first portion of the duodenum and pancreatic head
- A curvilinear or cystic fluid collection in the groove — subtle but classic
- Pancreatic and/or bile duct dilatation may be present
MRI/MRCP findings:
- Hypovascular plate-like lesion in the groove
- Pathognomonic cystic changes within the lesion on T2-weighted imaging (see Fig. 25.23 D below)
- MRCP is important in the workup — shows both the hypovascular lesion and the cysts
Fig. 8 (Current Surgical Therapy 14e) — (A) shows groove pancreatitis with diffuse stranding/inflammatory changes around the duodenum and pancreatic head, with a 2.9-cm hypodense fluid collection (arrow):

Fig. 25.23 (Grainger & Allison's) — MRI demonstrating the hypovascular groove mass (C) with the characteristic T2 cystic changes (D, arrow):

Diagnostic Challenge: Mimicking Cancer
The solid subtypes (1A/1B) are most often misdiagnosed as pancreatic adenocarcinoma preoperatively due to overlapping imaging features. Key points:
- Tumor markers (CA 19-9, CEA) are often negative in groove pancreatitis — supports benign diagnosis
- EUS-guided biopsy is often required to corroborate the diagnosis
- Cytology can be misleading — pancreatoduodenectomy is sometimes performed to definitively exclude malignancy — Current Surgical Therapy 14e, p. 669; Grainger & Allison's, p. 692
A stricture of the main pancreatic duct and/or common bile duct is found in ~72.5% and ~57% of cases respectively on endoscopic evaluation. — Clinical GI Endoscopy 3e, p. 3890
Management
| Approach | Details |
|---|---|
| Conservative / supportive | For biopsy-proven cases — alcohol cessation, analgesia, nutritional support |
| Endoscopic therapy | Pancreaticobiliary stenting + EUS-guided transduodenal drainage of periduodenal fluid collections ± subcutaneous octreotide. Clinical success >70% in case series |
| Surgery (pancreatoduodenectomy) | Required when duodenal or biliary obstruction is not manageable endoscopically, or when malignancy cannot be excluded — Yamada's Textbook of Gastroenterology; Clinical GI Endoscopy 3e |
Summary
Groove pancreatitis is a rare but important entity to recognize — its location in the pancreaticoduodenal groove, characteristic cystic changes on MRI, and strong association with alcohol/tobacco use help distinguish it from pancreatic cancer. When imaging features are equivocal, EUS-FNA is the next step; surgical resection may ultimately be needed both for symptom control and diagnostic certainty.
Please explain in detail
Finding Sources
Finding Sources
Reading File
Reading File
Finding Sources
Finding Sources
Reading File
Reading File
Loading Image
Loading Image
Here is a detailed account of groove pancreatitis, drawn from Current Surgical Therapy 14e, Grainger & Allison's Diagnostic Radiology, and Clinical Gastrointestinal Endoscopy 3e.
Groove (Paraduodenal) Pancreatitis — Detailed Review
1. Terminology & Historical Context
Groove pancreatitis has accumulated several names over the decades:
- Groove pancreatitis — original descriptive term referring to the anatomical groove where inflammation occurs
- Paraduodenal pancreatitis — now the preferred term, reflecting the location adjacent to the duodenum
- Cystic dystrophy of the duodenum — an older term emphasizing the cystic wall changes in the duodenum
These names all describe the same disease: a distinct form of chronic pancreatitis that predominantly and selectively affects the pancreatic groove — the anatomical space bounded by the head of the pancreas, the descending (second) part of the duodenum, and the common bile duct. — Grainger & Allison's, p. 689
2. Anatomy of the "Groove"
The pancreatic groove is a potential space situated:
- Anteriorly: the descending (second) part of the duodenum
- Medially: the head of the pancreas
- Posteriorly/superiorly: the common bile duct
The inflammation in groove pancreatitis specifically targets this interface — the tissue between the major papilla (ampulla of Vater) and the minor papilla (accessory pancreatic duct opening) — and may extend into the duodenal wall itself. This is why duodenal wall thickening, cystic changes within the duodenal wall, and duodenal stenosis are hallmark features. — Current Surgical Therapy 14e, p. 669
3. Epidemiology & Risk Factors
- Predominantly affects middle-aged males
- Strong association with chronic heavy alcohol use and tobacco smoking — the same risk factors as classical chronic pancreatitis
- Less common than other forms of chronic pancreatitis, but clinically important because of its strong resemblance to pancreatic head cancer
4. Pathogenesis
The exact mechanism is incompletely understood, but the leading hypothesis involves:
- Obstruction of the minor papilla (accessory duct): Alcohol/tobacco cause inspissation of secretions and ductal protein plugs → obstruction of the accessory pancreatic duct → pressure buildup in the groove → repeated episodes of local inflammation
- Aberrant pancreatic heterotopia in the duodenal wall: Some cases arise from ectopic pancreatic tissue within the duodenal wall that undergoes inflammatory degeneration
- Periductal fibrosis: Progressive fibrosis around the minor papilla leads to the plate-like fibrous mass seen on imaging
The result is a chronic fibroinflammatory process with fibrous scar tissue, cyst formation, and duodenal wall remodeling confined predominantly to the groove, with the main pancreatic parenchyma relatively spared (in the groove-predominant form). — Grainger & Allison's, p. 689–692
5. Pathological Subtypes
Recent studies established four subtypes based on extent and morphology:
| Subtype | Description | Key Feature |
|---|---|---|
| Type 1A | Solid, groove-predominant | Fibrous mass between duodenum and pancreatic head |
| Type 1B | Solid, pancreas-involving | Mass extends into pancreatic head — cancer mimic |
| Type 2A | Cyst-forming, groove-predominant | Classic appearance — cysts in the groove |
| Type 2B | Cyst-forming, pancreas-involving (segmental) | Cysts in groove + pancreatic head involvement |
On imaging, these resolve into two practical patterns:
- Groove-predominant form: lesion confined to the groove, pancreatic parenchyma largely normal
- Segmental (pancreas-involving) form: lesion also involves the pancreatic head, making it nearly indistinguishable from pancreatic ductal adenocarcinoma — Grainger & Allison's, p. 692
6. Clinical Presentation
Patients typically present with a triad:
a) Abdominal Pain
- Persistent, severe, often epigastric, radiating to the back
- Chronic and relapsing — similar to other forms of chronic pancreatitis
b) Biliary Obstruction
- Obstructive jaundice — from compression or fibrotic involvement of the common bile duct passing through the inflamed groove
- May be the presenting symptom that triggers imaging
c) Gastric Outlet / Duodenal Obstruction
- Duodenal wall thickening and fibrosis → duodenal stenosis
- Manifests as early satiety, nausea, vomiting, postprandial pain
- Can be severe enough to require intervention — Current Surgical Therapy 14e, p. 669; Clinical GI Endoscopy 3e, p. 3890
Additional findings:
- Weight loss (from reduced oral intake / malabsorption)
- Features of chronic pancreatitis (calcifications, parenchymal atrophy) in >35% of patients
- Pancreatic exocrine insufficiency may develop over time
7. Laboratory Findings
- Tumor markers (CA 19-9, CEA) are typically negative or only mildly elevated — this is a key distinguishing point from pancreatic cancer, though not absolute
- Serum amylase/lipase may be mildly elevated or normal in the chronic phase
- Liver function tests may show obstructive pattern (elevated bilirubin, alkaline phosphatase, GGT) if biliary obstruction is present
- No specific serologic marker for groove pancreatitis
8. Imaging
CT Scan
- Groove-predominant form: plate-like, hypoattenuating (low-density), poorly enhancing lesion situated between the pancreatic head and the descending duodenum (labeled "D" in the CT below — arrows point to the mass)
- Diffuse stranding and inflammatory changes surrounding the first portion of duodenum
- A curvilinear or cystic fluid collection in the groove — subtle but classic for groove pancreatitis
- Pancreatic and/or bile duct dilatation may be present
- The main pancreatic parenchyma is largely unaffected (groove-predominant form)
- Segmental form: the low-density mass extends into and involves the pancreatic head — difficult to distinguish from carcinoma
Fig. 25.23A (Grainger & Allison's) — CT showing the low-density groove mass (arrows) between the pancreatic head and duodenum (D):
Fig. 8A (Current Surgical Therapy 14e) — CT showing groove pancreatitis with diffuse inflammatory stranding around the duodenal head and a 2.9-cm hypodense fluid collection (arrow):

MRI / MRCP
MRI is the most informative modality for groove pancreatitis:
- T1 GRE fat-suppressed: hypovascular (low signal) plate-like mass in the groove
- T2-weighted TSE: pathognomonic small cystic changes within the groove mass and in the duodenal wall — this cystic pattern is what distinguishes it most clearly from cancer
- MRCP additionally shows the cysts and any associated ductal changes
Fig. 25.23 C-D (Grainger & Allison's) — Gadolinium-enhanced T1 shows hypovascular groove mass (C, arrow); T2 shows the characteristic cysts (D, arrow):

Fig. 25.24 (Grainger & Allison's) — Segmental form: T1 in-phase (A) and gadolinium-enhanced T1 (B) show a large mass involving the pancreatic head (arrows); T2 (C) shows multiple small cysts in the groove and head; MRCP (D) delineates the cysts clearly (arrow):

EUS (Endoscopic Ultrasound)
- Excellent for characterizing the groove lesion and the duodenal wall
- EUS-guided fine-needle aspiration (FNA) / biopsy is the key tool for tissue diagnosis when cancer cannot be excluded — Grainger & Allison's, p. 692; Current Surgical Therapy 14e, p. 669
9. Differential Diagnosis
The most critical differential is pancreatic ductal adenocarcinoma (PDAC). The solid subtypes (1A, 1B) are frequently misdiagnosed as cancer preoperatively.
| Feature | Groove Pancreatitis | Pancreatic Cancer |
|---|---|---|
| Location | Strictly in the groove (early) | Often in pancreatic parenchyma |
| Cysts on T2/MRCP | Yes — pathognomonic small cysts | Rarely |
| Main duct | Often not obstructed (groove-predominant) | Abrupt obstruction ("double duct sign") |
| CA 19-9 | Usually negative | Usually elevated |
| Enhancement | Hypovascular, delayed | Hypovascular |
| Duct-penetrating sign | May be present | Absent (duct obstructed) |
| Duodenal wall involvement | Characteristic | Uncommon |
| Response to alcohol cessation | May improve | No response |
Other differentials include: ampullary carcinoma, duodenal carcinoma, autoimmune pancreatitis (type 1), and inflammatory pseudotumor. The focal inflammatory pseudotumor in chronic pancreatitis (the "duct-penetrating sign" — where the main duct traverses the mass) can also simulate cancer. — Grainger & Allison's, p. 692, 982
10. Management
Conservative (First-line)
- Alcohol and tobacco cessation — essential
- Analgesics (step-up from NSAIDs to opioids for pain control)
- Nutritional support (pancreatic enzyme replacement if exocrine insufficiency)
- This is the treatment of choice when diagnosis is confirmed by biopsy
Endoscopic Therapy
For patients with biliary/pancreatic ductal strictures or periduodenal fluid collections:
- Pancreatic duct stenting — for main pancreatic duct strictures (~72.5% of cases have MPD stricture)
- Biliary stenting — for common bile duct obstruction (~57% of cases)
- EUS-guided transduodenal drainage of periduodenal cystic collections
- Subcutaneous octreotide as an adjunct (reduces pancreatic secretion)
- Reported clinical success rate >70% with combined endoscopic/medical therapy — Clinical GI Endoscopy 3e, p. 3890
Surgery — Pancreatoduodenectomy (Whipple Procedure)
Indicated in two scenarios:
- Malignancy cannot be excluded — given the significant overlap with pancreatic cancer in the segmental form, resection is sometimes necessary as both a therapeutic and diagnostic maneuver
- Failed conservative/endoscopic management — persistent biliary or duodenal obstruction not amenable to endoscopic therapy, or refractory pain
- Cytology from EUS-FNA may be misleading (false negative or non-diagnostic), leading to surgery — Current Surgical Therapy 14e, p. 669; Yamada's Textbook of Gastroenterology
11. Key Teaching Points
- Location is the key: inflammation confined to the anatomical groove between the pancreatic head and the descending duodenum — not diffuse pancreatitis
- Cystic changes within the groove on T2 MRI are pathognomonic — look for small cysts in the groove and duodenal wall
- Alcohol + male sex = typical patient profile
- Negative tumor markers + absence of main duct obstruction + T2 cysts favor groove pancreatitis over cancer
- The segmental form is the great mimic of pancreatic cancer — EUS-FNA is needed; surgery may still be required
- Management is a stepwise approach: conservative → endoscopic → surgical (Whipple)
Sources: Current Surgical Therapy 14e, p. 669 | Grainger & Allison's Diagnostic Radiology, pp. 689–694, 982 | Clinical Gastrointestinal Endoscopy 3e, p. 3890
This is a shared conversation. Sign in to Orris to start your own chat.